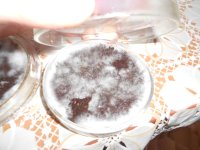
DSCN4103.JPG
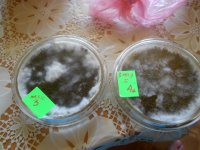
DSCN4104.JPG
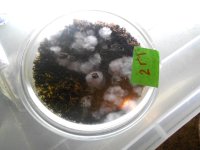
DSCN4113.JPG

меня просили написать как я готовлю агар и где я его беру.
Агар-самый простой ,кондитерский покупался еще в 2011 году,срок его паспортной годности вышел в 2013 году)) но я им еще работаю и не без результатно))
итак на 4 чашки петри я варю вот такую банку от детского питания ,это емкость 150 грамм.

Очень нажористая и питательная среда !!
в нее входят (насыпаем)
1-чайная с небольшой горкой ложка агара кондитерского
пол чайной ложки крахмала картофельного
1 чайная ложка с небольшой горкой первосортной муки
пол-чайной ложки сахара песка
на кончике ножа немного сухих дрожжей
все это засыпаем в банку,приливаем грамм 50 воды и размешиваем чтоб растворились все комочки,потом доливаем до 120 грамм ,еще воды любой хоть кипяченной хоть нет, и размешиваем,накрываем самодельной крышкой из фольги и ставим кипятить в кастрюльку с водой как банки для иннокуляции споровой взвесью с зерном ,кипятим после закипания 45 минут ,потом вытягиваем баночку и ставим ее остужаться при комнатной температуре минут 25 ть чтоб смесь была теплой ,если разлить горячей то будет потом много конденсата ,он и так будет ,но меньше намного .Разливайте по 5-6 мм слоем в каждую чашку и сразу закрывайте ее ,оставьте на пару часов застыть и остудится до комнатн температуры.
Перед всей "варкой " ,подготовьте чашки петри,помойте их с моющим и оставте их на чистом и мытом подносе стекать к верх дном все ставятся части чашек ,через 15 мин вытрите их чистым полотенцем или бумажным полотенцем ,и соедините части чашек верх и низ залив в каждую по 1 куб спирта если есть,через 30-45 мин пока варится агар там будет очень чистая среда))
все работы с засевами я провожу над газовой горелкой газовой печи) без глав бокса))
Часть вторая ,Агаровая среда меньшей питательности
1 ложка столовая гречки-вывариваем ее в 150 граммах воды минут 15 протомив на медленном огне,снимаем ,отстаиваем минут 15 чтоб осел осадок. потом аккуратно сливаем так чтобы не пролился осадок в наш раствор -осадок выкидываем нафик
между этим готовим
1 чайная ложка с небольшой горкой агара
пол чайной ложки картофельного крахмала
и воды примерно 70 грамм ,размешиваем,доводим всю эту мешанину до 100-120 грамм ,ставим банку с крышкой из фольги в кастрюльку и так же кипятим после закипания минут 45 ,потом вытаскиваем и остужаем минут 35-разливаем по чашкам петри
продолжение будет